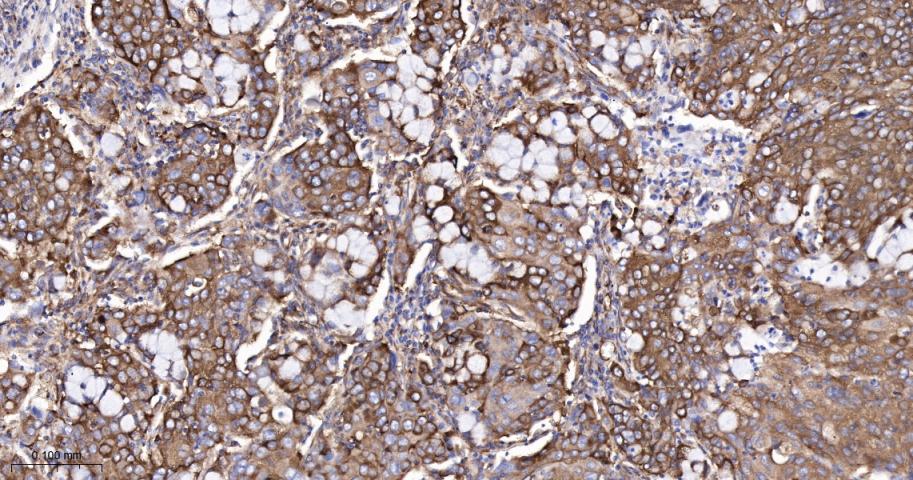
核酸酶敏感元件结合蛋白1重组兔单抗
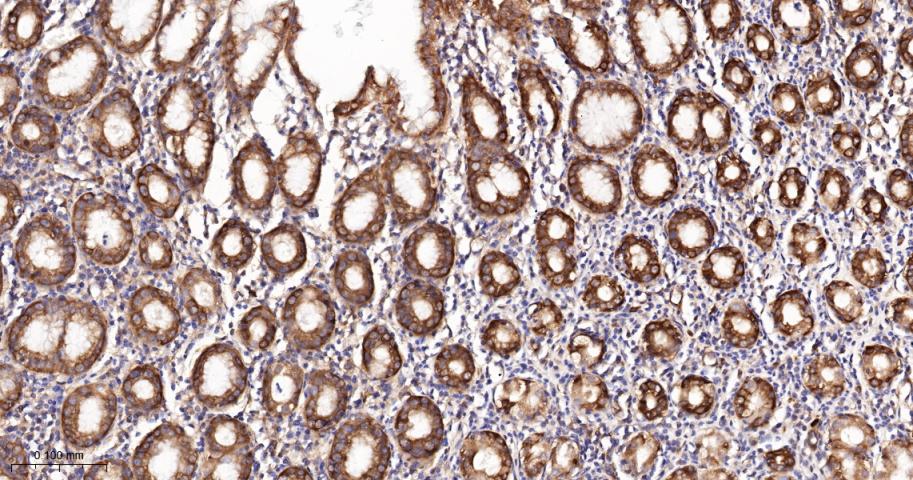
核酸酶敏感元件结合蛋白1重组兔单抗
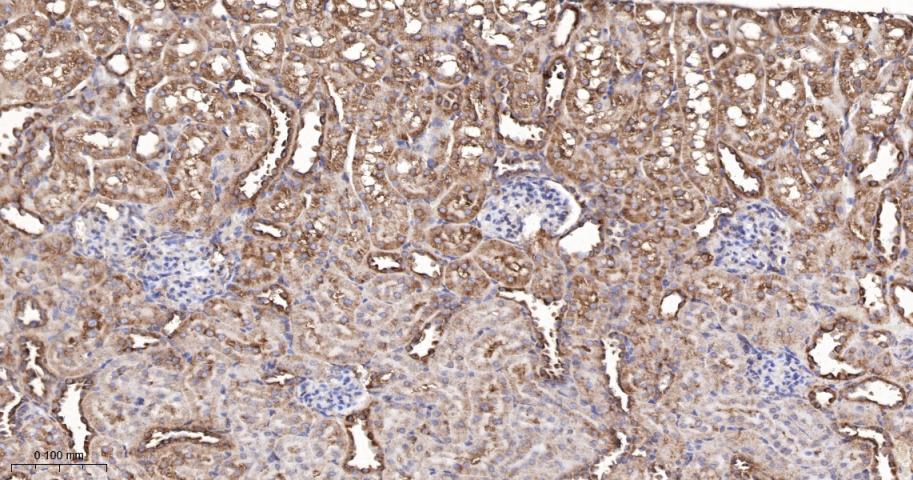
核酸酶敏感元件结合蛋白1重组兔单抗

YB1 Recombinant Rabbit mAb (一抗) - WB,IHC-P,IHC-F,IF,Flow-Cyt,ICC/IF,IP | Bioss
Rrmab?兔单抗

货号:bsm-61192R
产品详情
相关标记
相关产品
相关文献
常见问题
概述
产品编号
bsm-61192R
产品类型
重组兔单抗、mIHC精品抗体
英文名称
YB1 Recombinant Rabbit mAb
中文名称
核酸酶敏感元件结合蛋白1重组兔单抗
英文别名
BP-8; CBF-A; CSDA2; CSDB; DBPB; EFI-A; MDR-NF1; NSEP-1; NSEP1; YB-1; YB1; 1700102N10Rik; EF1A; MSY1; mYB-1a; Byb1; Cbfa; YBOX1_HUMAN; YBX1; CCAAT-binding transcription factor I subunit A (CBF-A); DNA-binding protein B (DBPB); Enhancer factor I subunit A (EFI-A); Nuclease-sensitive element-binding protein 1; Y-box transcription factor; YBOX1_MOUSE; Msy-1; YBOX1_RAT; Y-box binding protein 1; nuclease sensitive element binding protein 1
抗体来源
Rabbit
免疫原
A synthesized peptide derived from human YBX1: 280-324/324
亚型
IgG
性状
Liquid
纯化方法
affinity purified by Protein A
克隆类型
Recombinant
克隆号
15E6
理论分子量
36 kDa
检测分子量
47 kDa
储存液
10mM phosphate buffered saline(pH 7.4) with 150mM sodium chloride, 0.05% BSA, 0.02% Proclin300 and 50% glycerol.
研究领域
SWISS
Gene ID
保存条件
Store at 4℃ for short term. Store at -20℃ for long term. Avoid repeated freeze/thaw cycles.
注意事项
This product as supplied is intended for research use only, not for use in human, therapeutic or diagnostic applications.
数据库链接
背景资料
DNA- and RNA-binding protein involved in various processes, such as translational repression, RNA stabilization, mRNA splicing, DNA repair and transcription regulation.

产品应用
| 应用 | 已检合格种属 | 预测种属 | 推荐稀释比例 |
|---|---|---|---|
| WB | Human, Mouse, Rat | 1:500-2000 | |
| IHC-P | Human, Mouse, Rat | 1:100-500 | |
| IHC-F | Human, Mouse, Rat | 1:100-500 | |
| IF | Human, Mouse, Rat | 1:100-500 | |
| Flow-Cyt | Human | Mouse, Rat | 1:100-200 |
| ICC/IF | Human | Mouse, Rat | 1:100-200 |
| IP | Human, Mouse, Rat | 1:50-100 |
交叉反应
交叉反应: Human, Mouse, Rat
相关产品
暂无相关产品
靶标
基因名
YBX1
蛋白名
Y-box-binding protein 1
亚基
Identified in a histone pre-mRNA complex, at least composed of ERI1, LSM11, SLBP, SNRPB, SYNCRIP and YBX1 (By similarity). Component of the coding region determinant (CRD)-mediated complex, composed of DHX9, HNRNPU, IGF2BP1, SYNCRIP and YBX1. Identified in a mRNP complex, at least composed of DHX9, DDX3X, ELAVL1, HNRNPU, IGF2BP1, ILF3, PABPC1, PCBP2, PTBP2, STAU1, STAU2, SYNCRIP and YBX1. Identified in a mRNP granule complex, at least composed of ACTB, ACTN4, DHX9, ERG, HNRNPA1, HNRNPA2B1, HNRNPAB, HNRNPD, HNRNPL, HNRNPR, HNRNPU, HSPA1, HSPA8, IGF2BP1, ILF2, ILF3, NCBP1, NCL, PABPC1, PABPC4, PABPN1, RPLP0, RPS3, RPS3A, RPS4X, RPS8, RPS9, SYNCRIP, TROVE2, YBX1 and untranslated mRNAs. Component of the U11/U12 snRNPs that are part of the U12-type spliceosome. Interacts with IGF2BP1 and RBBP6. Component of cytoplasmic messenger ribonucleoprotein particles (mRNPs). Interacts with AKT1, MBNL1, SFRS9, ALYREF/THOC4, MSH2, XRCC5, WRN and NCL. Can bind to DNA as a homomeric form, (EFI-A)n or as a heteromeric form in association with EFI-B. Homodimer in the presence of ATP. Interacts (via C-terminus) with APEX1 (via N-terminus); the interaction is increased with APEX1 acetylated at 'Lys-6' and 'Lys-7'. Interacts with EIF2C1 and EIF2C2.
亚细胞定位
Cytoplasm. Nucleus. Cytoplasmic granule. Secreted. Note=Localized in cytoplasmic mRNP granules containing untranslated mRNAs. Shuttles between nucleus and cytoplasm. Predominantly cytoplasmic in proliferating cells. Cytotoxic stress and DNA damage enhance translocation to the nucleus. Localized with DDX1, MBNL1 and TIAL1 in stress granules upon stress. Secreted by mesangial and monocytic cells after inflammatory challenges. Translocates from the cytoplasm to the nucleus after and colocalizes with APEX1 in nuclear speckles after genotoxic stress.
翻译后修饰
Ubiquitinated by RBBP6; leading to a decrease of YBX1 transcactivational ability.
In the absence of phosphorylation the protein is retained in the cytoplasm.br
In the absence of phosphorylation the protein is retained in the cytoplasm.br
相似性
Contains 1 CSD (cold-shock) domain.
功能
Mediates pre-mRNA alternative splicing regulation. Binds to splice sites in pre-mRNA and regulates splice site selection. Binds and stabilizes cytoplasmic mRNA. Contributes to the regulation of translation by modulating the interaction between the mRNA and eukaryotic initiation factors (By similarity). Regulates the transcription of numerous genes. Its transcriptional activity on the multidrug resistance gene MDR1 is enhanced in presence of the APEX1 acetylated form at 'Lys-6' and 'Lys-7'. Binds to promoters that contain a Y-box (5'-CTGATTGGCCAA-3'), such as MDR1 and HLA class II genes. Promotes separation of DNA strands that contain mismatches or are modified by cisplatin. Has endonucleolytic activity and can introduce nicks or breaks into double-stranded DNA (in vitro). May play a role in DNA repair. Component of the CRD-mediated complex that promotes MYC mRNA stability. Binds preferentially to the 5'-[CU]CUGCG-3' motif in vitro.
The secreted form acts as an extracellular mitogen and stimulates cell migration and proliferation.
The secreted form acts as an extracellular mitogen and stimulates cell migration and proliferation.
同靶标产品
相关文献
提示: 发表研究结果有使用 bsm-61192R 时请让我们知道,以便我们可以引用参考文章。作为回馈,资料提供者将获得我们送上的小礼品。